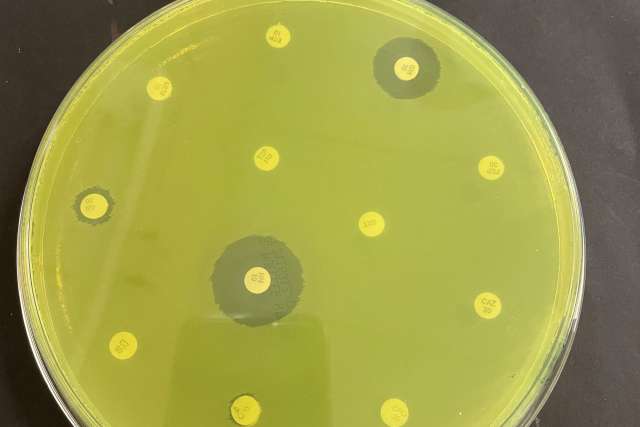
NDM PsA

It started quietly — with one ICU patient, one culture and one highly unusual result. The lab detected Pseudomonas aeruginosa, a common hospital-acquired bacterium, often found in moist environments. But this strain was different: It carried a gene called NDM-1, or New Delhi metallo-β-lactamase, an enzyme that breaks down carbapenems and other powerful beta-lactam antibiotics, rendering them ineffective.
“This was the first time we’d ever seen an NDM-1-producing Pseudomonas strain in our hospital — and in a patient with no international travel,” says Shangxin Yang, PhD, director of UCLA Health’s Molecular Microbiology and Pathogen Genomics Laboratory. “While NDM-1 is prevalent in Asia, Europe and the Middle East, it remains rare in the United States. That’s when we knew this wasn’t imported. This was something domestic — and very concerning.”
Over the next 18 months, seven more patients tested positive for the same rare, resistant strain. The cases appeared unrelated, spread out across time and hospital units, defying traditional outbreak patterns. After extensive investigation, the infection prevention and microbiology teams at UCLA Health traced the source to an unexpected place: a single ICU sink, contaminated and quietly harboring bacteria in its plumbing.
The findings were recently published in the American Journal of Infection Control in a study titled “Outbreak of New Delhi metallo-β-lactamase carbapenemase-producing Pseudomonas aeruginosa infections in a Southern California hospital.”
Looking for a link
When Dr. Yang’s team found the NDM-1 strain, he contacted Dan Uslan, MD, Chief Infection Prevention Officer at UCLA Health. Dr. Uslan and his team launched a comprehensive investigation to determine the source of the NDM-1 gene. Working in partnership with Dr. Yang’s microbiology team and public health, his team examined shared equipment, common nursing staff, respiratory therapy protocols and environmental surfaces.
Nothing definitive emerged. Then another case surfaced. And another.
“This wasn’t an obvious outbreak,” says Dr. Uslan. “The cases were scattered over time and didn’t share the same room or devices. That made it harder to identify the source.”
A powerful tool to track spread
To determine whether the cases were connected, Dr. Yang’s lab employed an advanced technique: whole-genome sequencing (WGS), which identifies the complete DNA signature of a bacterium.
“WGS allows us to compare pathogens at the individual level,” Dr. Yang explains. “We can detect drug resistance mutations, trace their origins and determine if infections came from a common source. It’s like pathogen forensics.”
Using WGS, the team discovered that seven of the eight cases — plus two sink isolates — shared nearly identical genetic profiles. Only one patient, who had received prior medical care in Iran, carried a genetically distinct strain.
A sink no one expected
The breakthrough came during a third round of intensive environmental testing. A contaminated ICU sink drain and P-trap yielded Pseudomonas aeruginosa with the same NDM-1 gene and genetic fingerprint as the patient isolates. Remarkably, patients 1 and 8 had both stayed in that room — more than a year apart.
How did the NDM-1 strain survive in the sink’s plumbing?
“Pseudomonas is especially adept at forming biofilms — protective layers that adhere to plumbing and shield bacteria from standard disinfectants,” says Dr. Uslan.
The biofilm protects it from routine cleaning and disinfection, so it becomes very difficult to eradicate a biofilm from a sink.
Stopping the outbreak
To stop the spread of NDM-1, the team implemented a series of targeted interventions.
First, they began weekly treatments with Virasept™, the only EPA-registered disinfectant proven to break down bacterial biofilms.
In addition to chemical disinfection, the team physically replaced the sink’s plumbing — including the P-trap — where bacteria like to reside, says Dr. Uslan.
Then the team adjusted the faucet angles so water no longer poured directly onto the drain, which can aerosolize droplets.
“Bacteria can spread directly from contaminated drains to health care workers’ hands during routine handwashing, or indirectly to patient surfaces. For example, water droplets can splash from the drain onto nearby items like food trays or medical supplies, creating opportunities for cross-contamination,” says Dr. Uslan.
Staff were also educated to keep all patient care supplies out of the sink’s splash zone.
To help prevent future outbreaks, the following measures were adopted across the ICU:
- Weekly Virasept treatments for all ICU sinks
- Faucet adjustments to minimize splash-back
- Staff education on keeping supplies outside of the sink’s splash zone
No additional infections have been reported since these interventions were implemented.
Lessons for other hospitals
This outbreak and the study underscore several important lessons for health care providers and systems:
- The importance of active pathogen surveillance, real-time testing, genomic testing and environmental hygiene in preventing the spread of dangerous superbugs in hospitals
- The insidiousness of Pseudomonas aeruginosa and its dangerous capacity to develop resistance to antibiotics and spread through hospital plumbing systems
- The power of teamwork
“We couldn’t have done it without the collaboration between infection prevention, microbiology and facilities,” Dr. Uslan says. “Everyone worked together to identify a hidden threat and eliminate it.”
To learn more, visit the UCLA Health Division of Infectious Diseases.